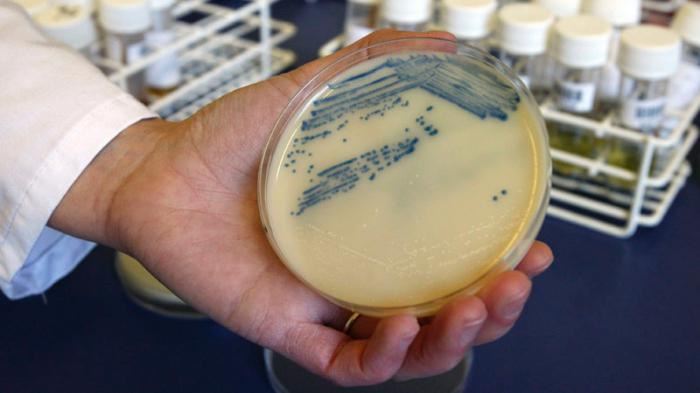

Активное составляющее Гексикон – это хорошо зарекомендовавшее себя антибактериальное и противовирусное вещество хлоргексидина биглюконат. Концентрация составляет 20% (в 100 мл содержится 0,25 мл действующего компонента). В качестве вспомогательного составляющего используется дистиллированная вода. Раствор не имеет цвета и запаха; он может быть прозрачным или немного опалесцирующим.
Препарат поставляется в аптечные сети в пластиковых флаконах различного объема (до 500 мл). Каждая емкость снабжена удобной дозирующей насадкой.
Эффективностьраствора Гексикона
Данный антисептик весьма эффективен в отношении огромного количества самых разнообразных бактерий (трепонемы, гарднеллы, уреаплазмы и т. д.), простейших, вирусов и дрожжеподобных грибков. Гексикон сохраняет активность в присутствии биологических жидкостей – гноя и крови.
Хлоргексидин не повреждает здоровые клеточные элементы и грануляционные ткани, и не оказывает отрицательного влияния на процесс краевой эпителизации раны. Экспериментально установлено, что Гексикон не вызывает аллергии и не обладает местно-раздражающим действием.
При случайном попадании раствора внутрь он практически не абсорбируется в органах пищеварительного тракта; 90% неизмененного вещества экскретируется через кишечник, а около 1% покидает организм с мочой.
После местного нанесения на травмированные области кожи и слизистых оболочек Гексикон внутрь не проникает.
Врачи отмечают, что Гексикон в форме раствора для наружного применения является эффективным средством для профилактики и лечения инфекций, вызванных бактериями и грибками. Его активное вещество, хлоргексидина биглюконат, обладает антисептическими свойствами, что позволяет быстро справляться с воспалительными процессами. Специалисты рекомендуют использовать Гексикон в случаях, когда необходимо снизить риск инфицирования после хирургических вмешательств или травм.
Однако врачи также подчеркивают важность соблюдения инструкции по применению, чтобы избежать возможных побочных эффектов. В случае необходимости можно рассмотреть аналоги, такие как Мирамистин или Дексан, которые также обладают антисептическими свойствами, но могут иметь разные показания и противопоказания. Важно, чтобы выбор препарата осуществлялся совместно с врачом, учитывая индивидуальные особенности пациента.

Когда нужно применять раствор?
Гексикон предназначен для профилактической обработки вероятно инфицированных ожогов, ран, ссадин и царапин.
К числу показаний также относится предупреждение ЗППП (венерических заболеваний) — гонореи; хламидиоза, сифилиса и многих других.
Важно
После незащищенного полового акта рекомендуется тщательно обработать гениталии раствором Гексикон. Вероятность инфицирования при этом многократно снижается.
Хлоргексидина биглюконат также широко используется в стоматологии (для обработки ротовой полости при стоматитах и гингивитах), урологии, хирургии, а также акушерско-гинекологической практике.
Когда Гексикон не назначается?
К числу противопоказаний относятся
- аллергия на препарат;
- кожные заболевания.
Важно
Осторожность важно соблюдать при обработке ран у детей.
Гексикон — это антисептический раствор, который широко используется для обработки кожных покровов и слизистых оболочек. Многие пользователи отмечают его эффективность в профилактике инфекций, особенно после хирургических вмешательств или травм. Инструкция по применению подчеркивает, что препарат подходит для наружного использования и не вызывает значительных побочных эффектов. Однако некоторые пациенты сообщают о легком жжении при нанесении, что не является критичным.
Среди аналогов Гексикона выделяют такие препараты, как Хлоргексидин и Мирамистин, которые также обладают антисептическими свойствами. Пользователи отмечают, что Гексикон имеет более мягкое действие и менее агрессивен по сравнению с некоторыми аналогами. В целом, отзывы о препарате в основном положительные, и многие рекомендуют его как надежное средство для профилактики инфекций.

Дозы и техника нанесения
Гексикон наносится местно в зависимости от конкретной ситуации.
На поврежденную кожу накладывают обильно смоченный тампон (5-10 мл раствора). Срок экспозиции – 1-3 минуты. Манипуляции целесообразно повторить дважды в сутки.
ПрофилактикаЗППП Гексиконом
Для профилактики ЗППП Гексикон нужно использовать не позже, чем через 2 ч. после полового акта с партнером. Мужчинам посредством насадки 2-3 мл антисептика водится в уретру, а женщинам – 1-2 мл в уретру + 5-10 мл интравагинально. Время экспозиции – 2-3 минуты.
Дополнительно нужно обильно обработать Гексикон зоны лобка, промежности, наружных гениталий и бедер. Целесообразно воздержаться от мочеиспускания на протяжении 2-3 часов.

Инструкция по применению Гексикон
При диагностированных уретропростатитах и уретритах требуется ежедневное впрыскивание хлоргескидина биглюконата в мочеиспускательный канал 1-2 раза в день по 3 мл. Продолжительность курса – 10 суток (с промежутками в 1 день).
При стоматологических заболеваниях (гингивиты, пародонтиты, афтозные стоматиты) назначаются полоскания 3-4 раза в день по 5-10 мл (после еды, тщательно очистив полость рта).
Вероятные побочные эффекты
Подавляющее большинство пациентов отлично переносят терапию Гексикон.
В редчайших случаях фиксируются быстропроходящие кожные аллергические реакции в виде красноватых высыпаний, повышенная сухость кожи и фотодерматиты.
При полосканиях в ходе терапии воспаления десен не исключены временное изменение вкусовых ощущений и окрашивание эмали зубов при наличии налета.
ПередозировкаГексикон
Поскольку абсорбция раствора незначительна, то передозировка невозможна.
Взаимодействие
Хлоргексидина биглюконат не совместим с мылами и детергентами, в состав которых входят анионные группы. Присутствие моющих веществ способно инактивировать антисептик.
Эффективность Гексикон возрастает в присутствии этилового спирта.
Дополнительно
Недопустимо обрабатывать хлоргексидином открытые ЧМТ, травмы спинного мозга и использовать раствор при нарушениях целостности барабанной перепонки.
При попадании Гексикон в глаза, их срочно следует промыть большим количеством проточной воды.
По мере повышения температуры раствора, его антисептический эффект возрастает, но при 100°С Гексикон частично разлагается.
Не следует параллельно использовать данный антисептик с растворами йода.
Беременность и лактация
Период вынашивания и грудного вскармливания малыша не являются противопоказаниями к использованию Гексикон.
Условия хранения и продажи
Раствор разрешен для отпуска без рецепта врача.
Рекомендованная температура хранения ≤25°С.
Срок годности составляет 3 года со дня выпуска, указанного на упаковке.
Беречь от детей.
Аналоги Гексикон по действующему веществу
- Хлоргексидин;
- Хлоргексидина биглюконат;
- Бельведер (крем для век);
- Амидент;
- Хлоргексидин С.
Плисов Владимир, врач, медицинский обозреватель
Вопрос-ответ
Как правильно использовать Гексикон для наружного применения?
Гексикон следует применять согласно инструкции: необходимо обрабатывать пораженные участки кожи или слизистых оболочек 2-3 раза в день. Перед использованием рекомендуется очистить область применения и дать высохнуть. Важно не превышать указанную дозировку и продолжительность курса лечения без консультации врача.
Какие существуют аналоги Гексикона и в чем их отличие?
Аналогами Гексикона являются препараты, содержащие хлоргексидин, такие как Хлоргексидин биглюконат и Мирамистин. Основное отличие заключается в концентрации активного вещества и форме выпуска. Например, Мирамистин может быть более эффективен против определенных видов бактерий и грибков, а также имеет более широкий спектр действия.
Можно ли использовать Гексикон во время беременности?
Гексикон считается безопасным для использования во время беременности, однако перед применением рекомендуется проконсультироваться с врачом. Он не проникает в системный кровоток и не оказывает негативного влияния на плод, но важно следовать рекомендациям специалиста для избежания возможных осложнений.
Советы
СОВЕТ №1
Перед использованием Гексикона обязательно ознакомьтесь с инструкцией. В ней содержатся важные сведения о показаниях, способах применения и возможных побочных эффектах, что поможет избежать нежелательных последствий.
СОВЕТ №2
Если у вас есть хронические заболевания или вы принимаете другие лекарства, проконсультируйтесь с врачом перед началом применения Гексикона. Это поможет избежать возможных взаимодействий и обеспечит безопасность лечения.
СОВЕТ №3
Обратите внимание на срок годности препарата. Использование просроченного Гексикона может привести к снижению его эффективности и негативным последствиям для здоровья.
СОВЕТ №4
Если после применения Гексикона вы заметили ухудшение состояния или появление аллергических реакций, немедленно прекратите использование и обратитесь к врачу. Быстрая реакция поможет предотвратить серьезные осложнения.